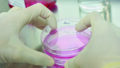

業界トップのアインHDが、2025年5月にさくら薬局(クラフト株式会社)の買収を公表しました。
かつてのアインHDの弱点は新参者だったことでしょう。大学病院など地域の代表的な医療施設は、先発の調剤薬局が好立地のもとで運営していました。店舗に適した空きがない状況の中で、アインHDは先発薬局チェーンを吸収合併して店舗を拡大してきました。
一方で新規出展は、限界に達しつつあるといわれています。さくら薬局の吸収合併は、自社の店舗網にはない財産を獲得しようとするものでしょう。
例えば、昭和大学病院(現昭和医科大学病院)の門前にはアイン薬局はなく、さくら薬局は2店舗あります。
また東京都千代田区のお茶の水駅周辺には東京科学大学病院(813床)、順天堂医院(1051床)、三楽病院、杏雲堂病院(191床)、日本大学病院(320床)などがあります。
アイン薬局は杏雲堂病院の前に「アイン薬局 三崎店」を設置しています。常勤薬剤師4名、非常勤薬剤師1名で総受取処方箋数20030件という規模の薬局です。
さくら薬局はそれぞれの病院の患者が集まるお茶の水駅橋口の直前に「さくら薬局 御茶ノ水駅前店」を運営しています。常勤薬剤師8名、総取扱処方箋48350件という規模です。
近年では病院の敷地内薬局が認められています。アイン薬局は、見積もり競争を勝ち抜いて大学病院などの敷地に出店してきました。他社も敷地内薬局に魅力を感じており、ドラッグストアとの見積もり競争では、負けることもあるようです。
オンライン調剤や外部委託などの流れがありますが、門前薬局も相変わらず機能しています。
調剤薬局業界の就職環境も変化し続ける
病院・薬局・Dgs・企業への就職